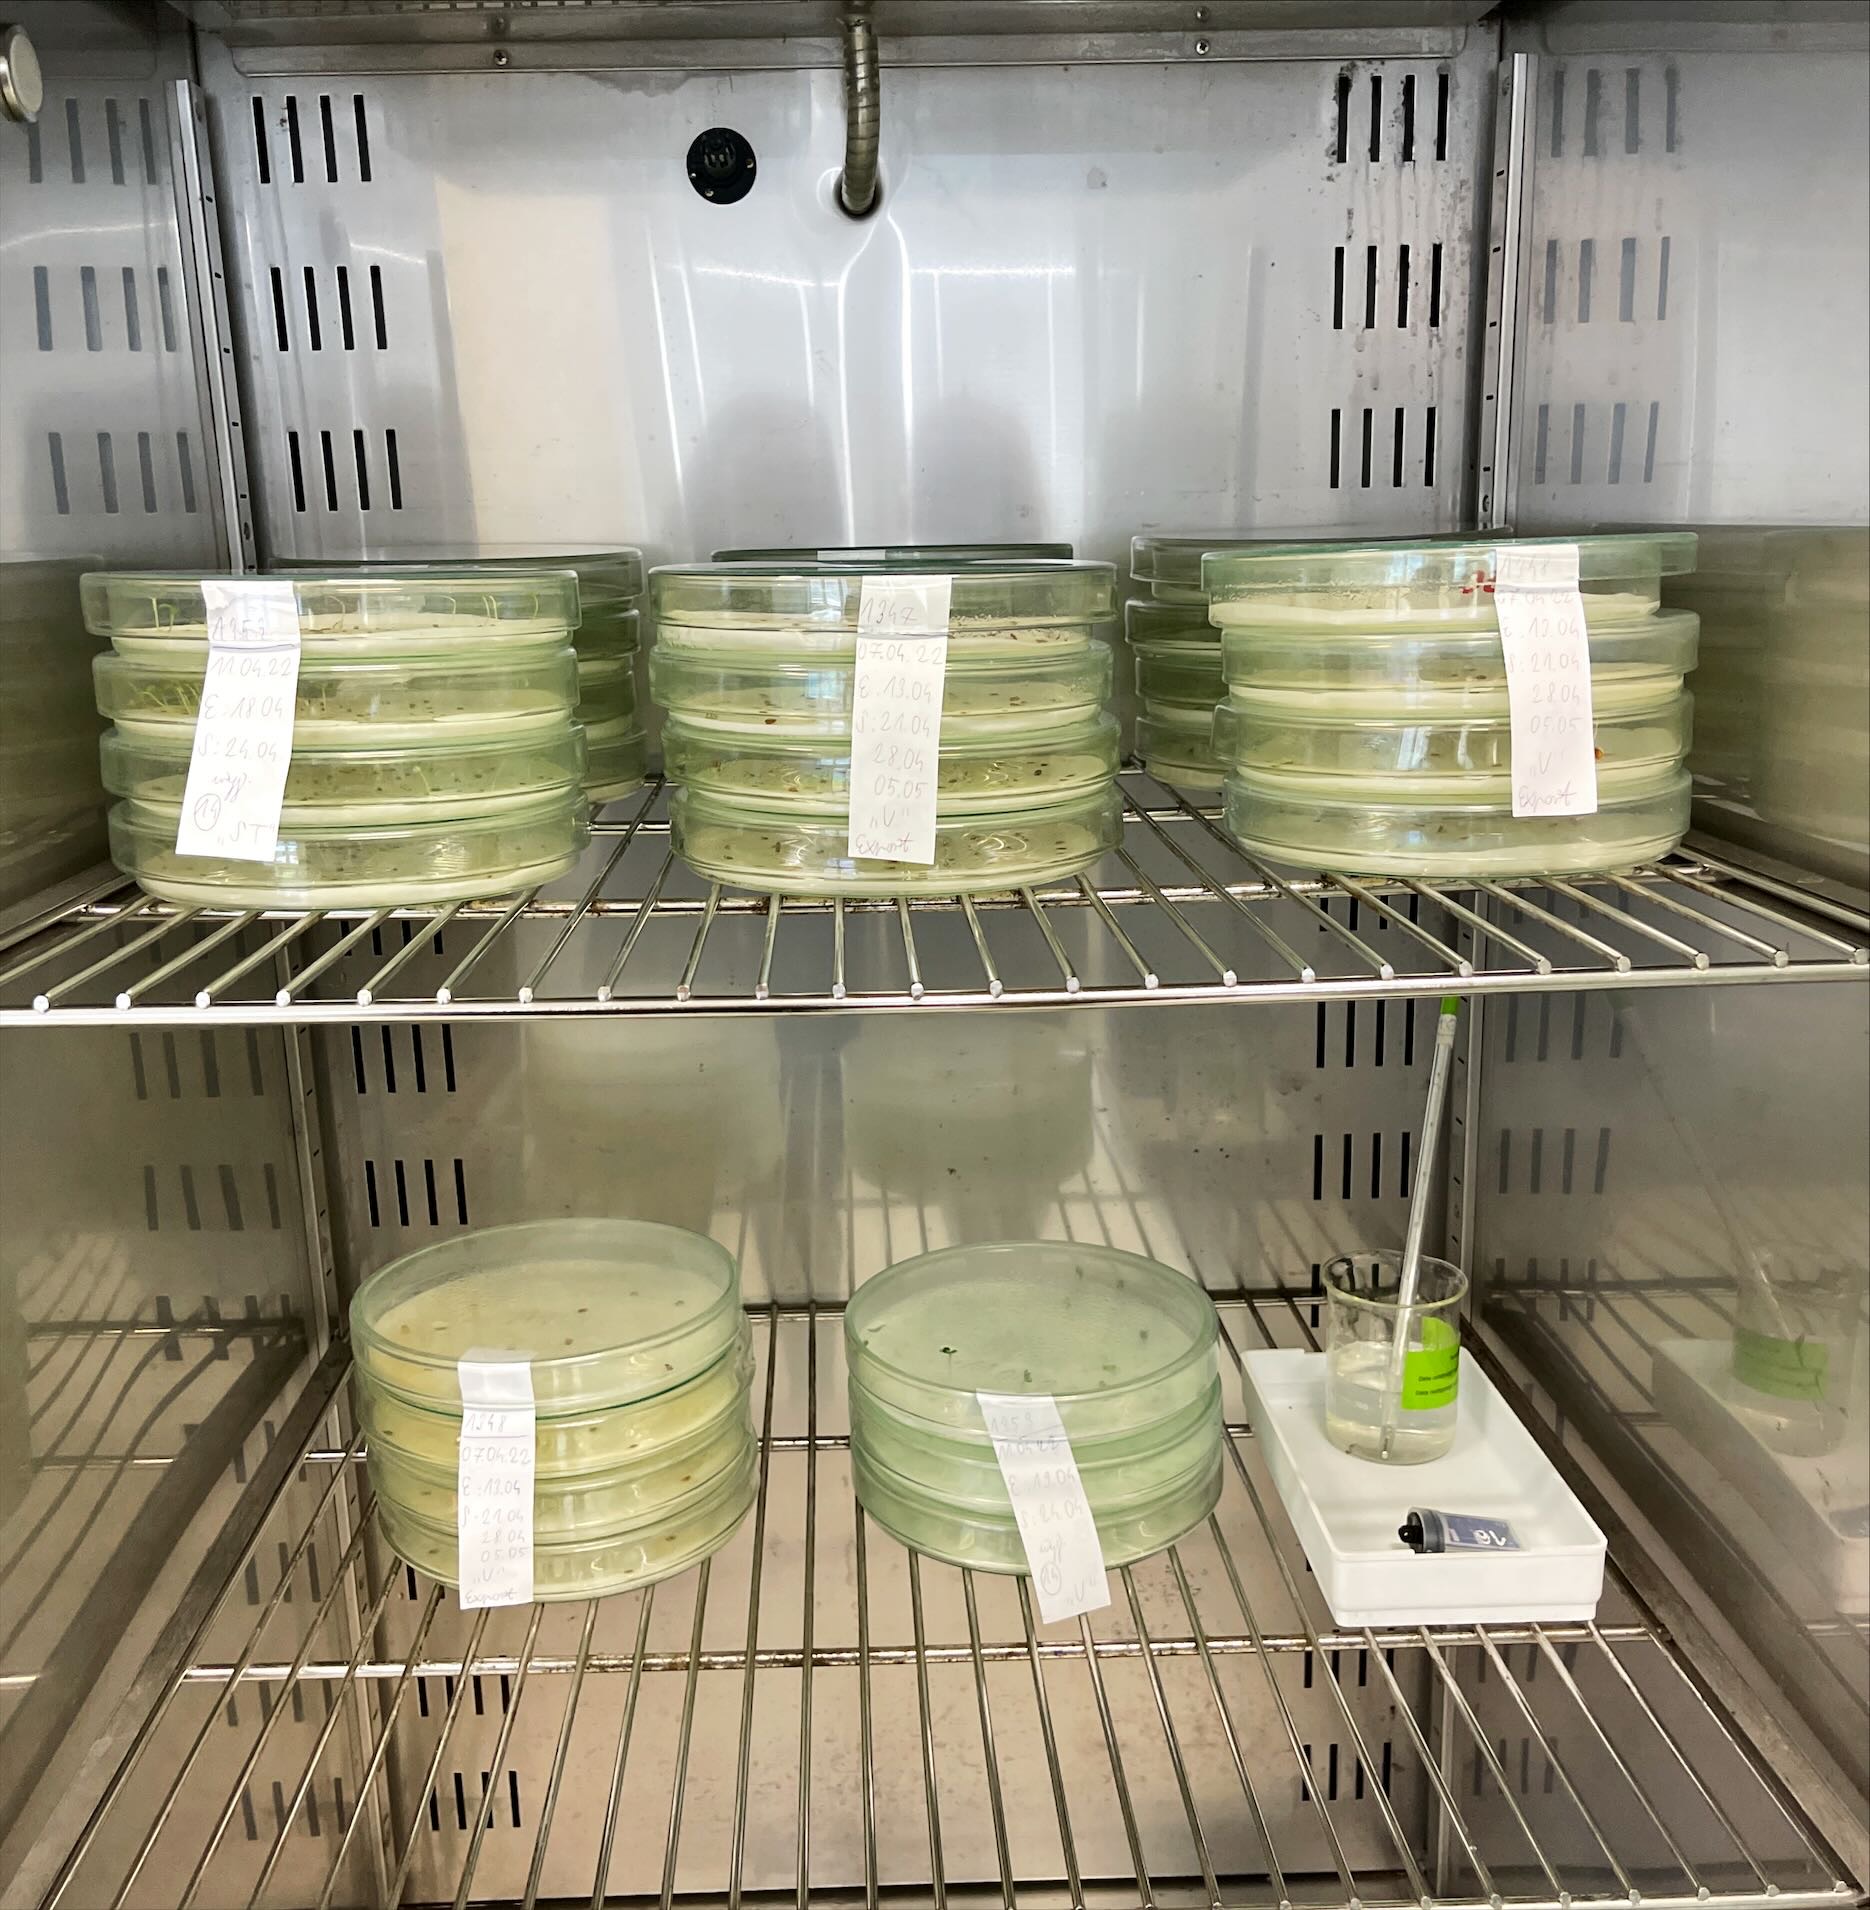

Wiosna w Laboratoriach Oceny Nasion
Wiosna to piękny czas w przyrodzie, a w laboratoriach zajmujących się oceną nasion również intensywny okres wykonywania badań, w szczególności oceny okresowej nasion warzyw. Są to partie nasion, będące w obrocie, które wymagają badania zdolności kiełkowania po upływie 1 roku od daty ostatniej oceny. Laboratoria przeprowadzają również badania oceny pierwotnej kwalifikatów, badania kontrolne materiału siewnego zlecone przez Działy Nadzoru Nasiennego oraz badania na zlecenie.

Badania laboratoryjne nasion są kluczowe dla oceny jakości materiału siewnego i przydatności do siewu, co ma bezpośredni wpływ na efektywność upraw i jakość plonów.
Materiał siewny roślin rolniczych i warzywnych będący w obrocie podlega ocenie przez analityków nasiennych w kilku etapach:
1. Przyjęcie próbki i rejestracja:
• zgodność wymaganych dokumentów: wniosek, zlecenie i protokół pobrania próbki,
• zgodność próbki nasion pod kątem odpowiedniej wielkości próbki i zabezpieczenia próbki.
2. Wydzielenie próbki zgodnie z aktualnymi Przepisami ISTA do analiz czystości nasion i zawartość nasion innych roślin w sztukach.
3. Ocena czystości:
• mikroskopowa ocena czystości materiału siewnego i rozdzielenie na frakcje: nasiona czyste, inne nasiona i zanieczyszczenia przy pomocy mikroskopu cyfrowego, zestawu podświetlającego ze sterownikiem i kolekcji nasion,
• naliczenie nasion do wysiewu ręcznie bądź za pomocą licznika nasion i wysiew na odpowiednich podłożach (S, BP, TP, PP) i w odpowiednich warunkach temperaturowych (15°C, 20°C, 20 - 30°C).
4. Oznaczenie Masy Tysiąca Nasion: naliczenie 8 x 100 nasion z frakcji nasion czystych.
5. Ocena zdolności kiełkowania:
• makroskopowa ocena siewek i klasyfikacja na poszczególne kategorie: siewki normalne,
• anormalne, nasiona twarde, martwe i zdrowe niekiełkujące.
6. Ocena żywotności nasion – topograficzny test tetrazolinowy do oceny żywotności próbek nasion wykazujących spoczynek pożniwny, bądź nasion spoczynkowych przy końcu testu kiełkowania.
Zdjęcia (13)
 Pokaż zdjęcie 2 z galerii.
Pokaż zdjęcie 2 z galerii.
 Pokaż zdjęcie 3 z galerii.
Pokaż zdjęcie 3 z galerii.
 Pokaż zdjęcie 4 z galerii.
Pokaż zdjęcie 4 z galerii.
 Pokaż zdjęcie 5 z galerii.
Pokaż zdjęcie 5 z galerii.
 Pokaż zdjęcie 6 z galerii.
Pokaż zdjęcie 6 z galerii.
 Pokaż zdjęcie 7 z galerii.
Pokaż zdjęcie 7 z galerii.
 Pokaż zdjęcie 8 z galerii.
Pokaż zdjęcie 8 z galerii.
Pokaż zdjęcie 9 z galerii.
Pokaż zdjęcie 9 z galerii.
 Pokaż zdjęcie 10 z galerii.
Pokaż zdjęcie 10 z galerii.
 Pokaż zdjęcie 11 z galerii.
Pokaż zdjęcie 11 z galerii.
 Pokaż zdjęcie 12 z galerii.
Pokaż zdjęcie 12 z galerii.
 Pokaż zdjęcie 13 z galerii.
Pokaż zdjęcie 13 z galerii.
